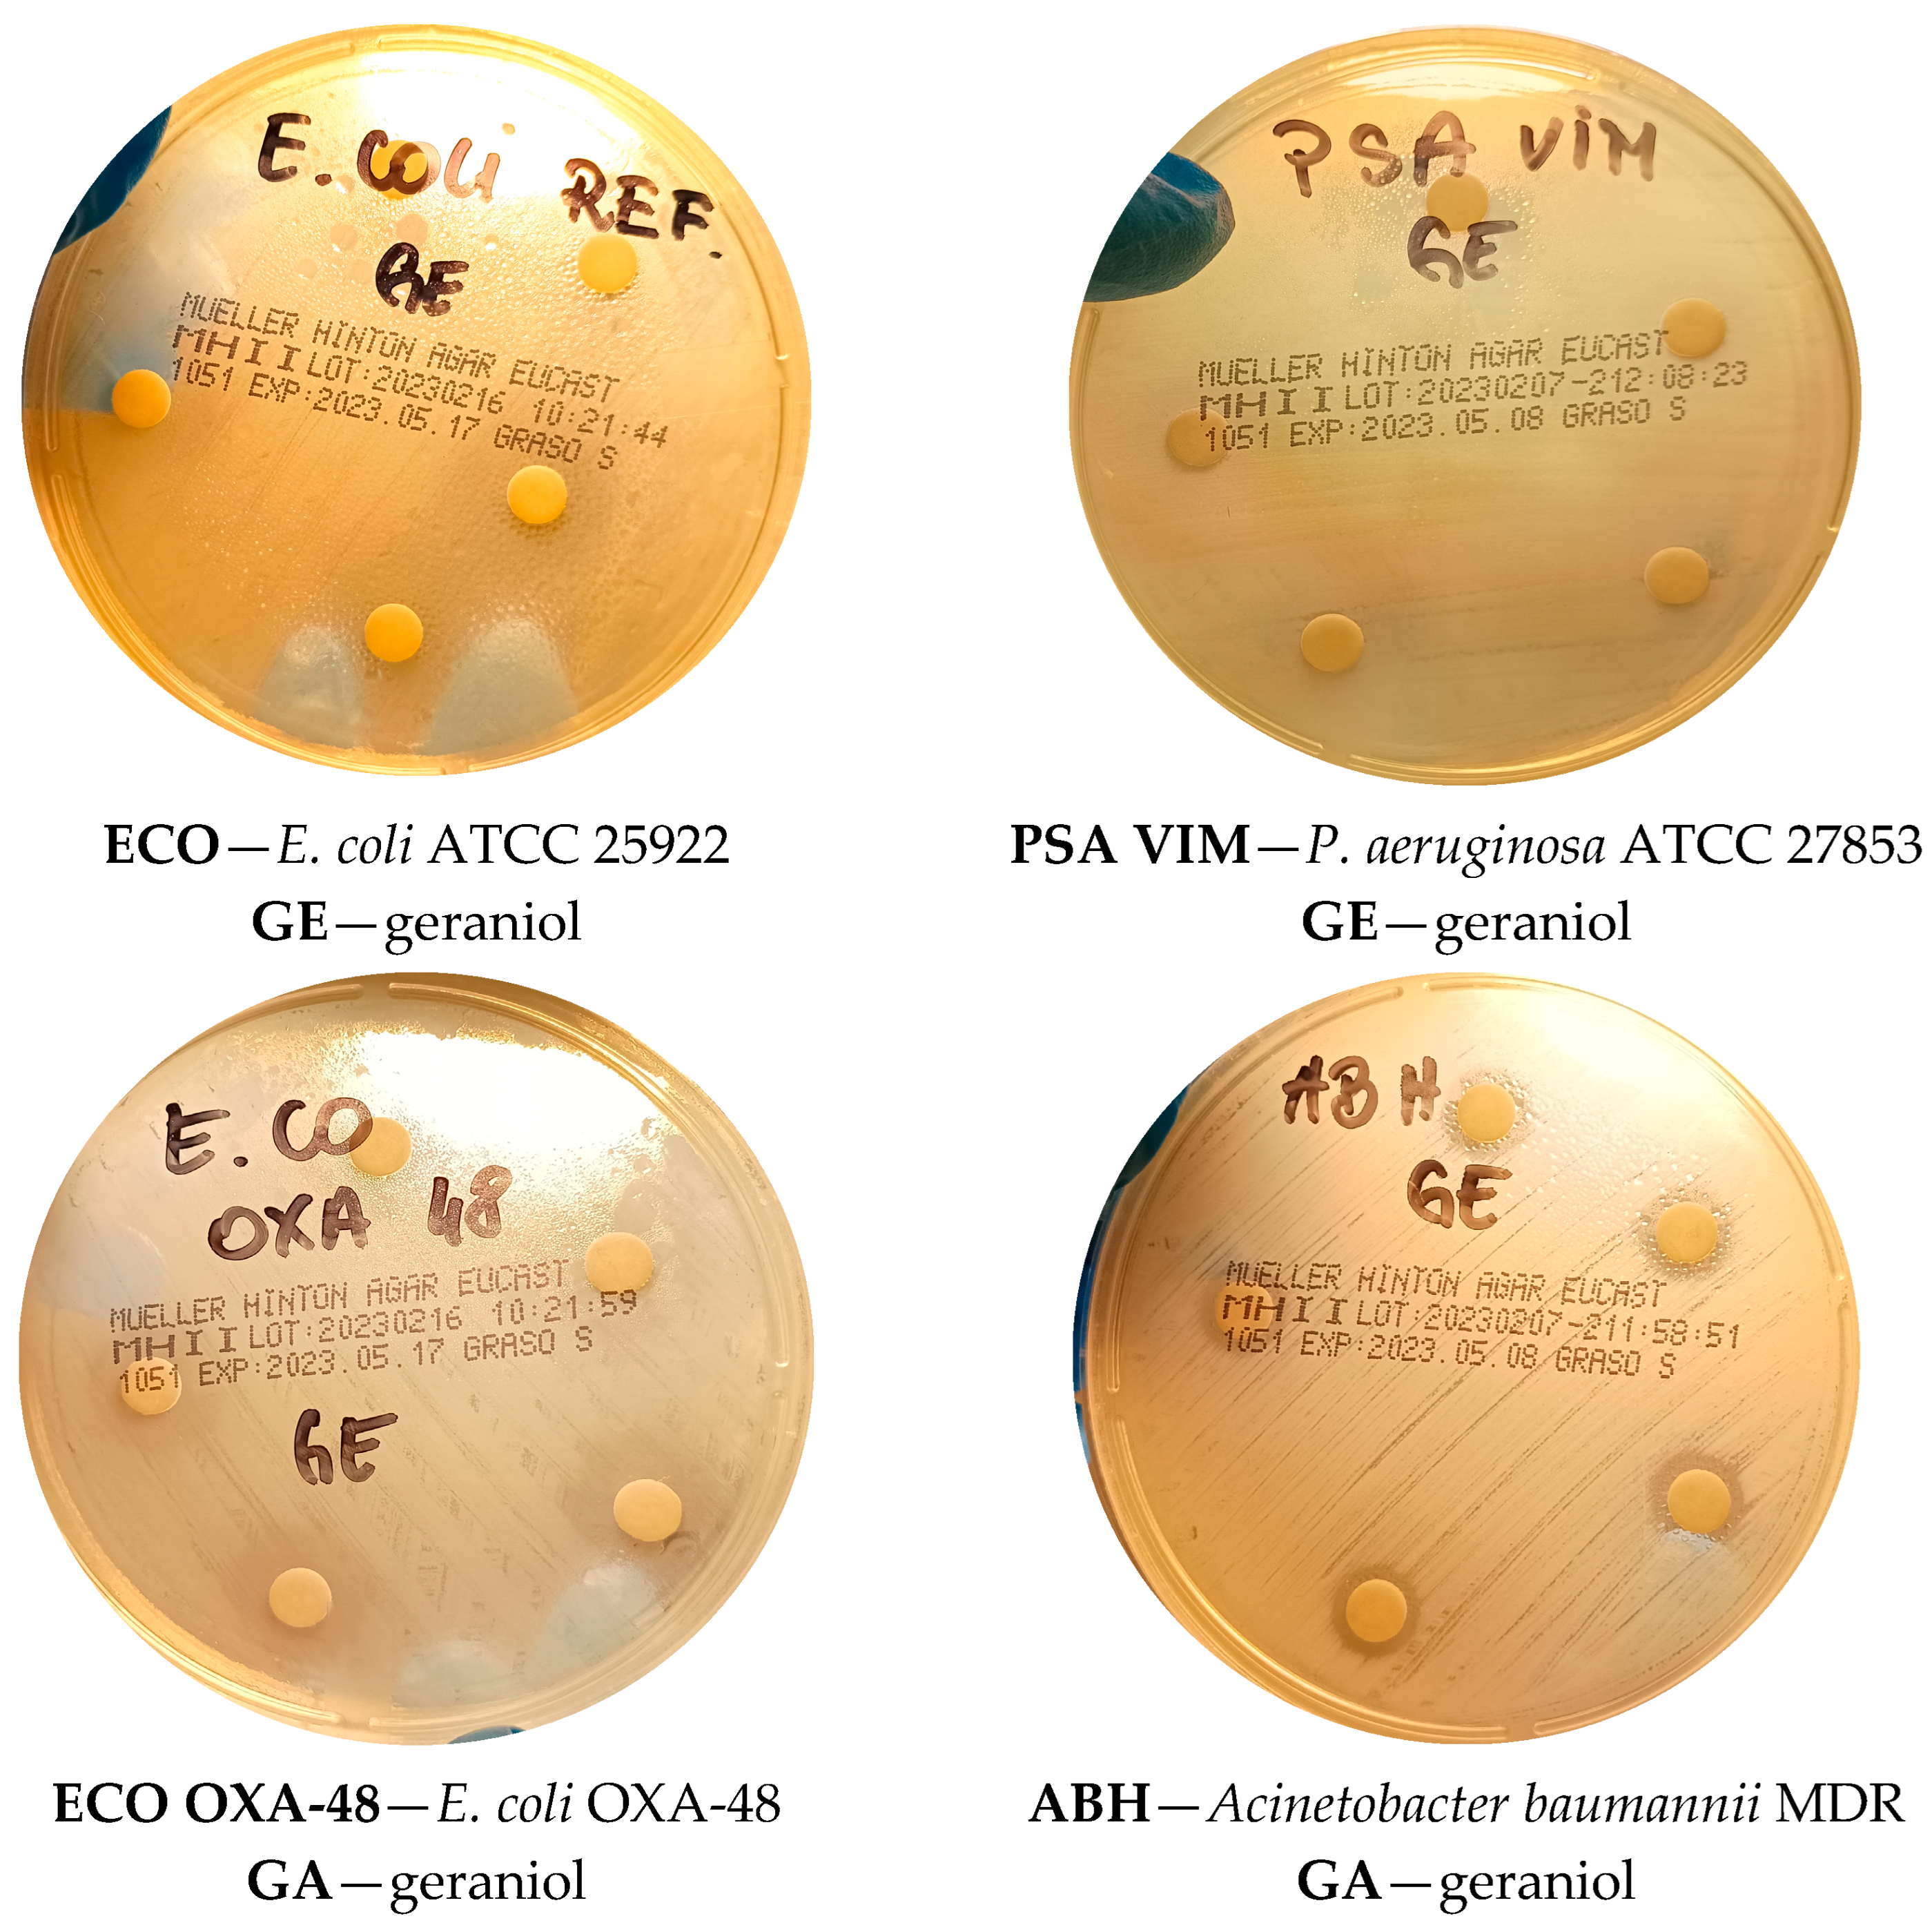
Applsci 15 09669 g004

1. Introduction
Antimicrobial resistance (AMR) has emerged as one of the most pressing global health challenges of the 21st century, posing significant threats to public health, clinical practice, and healthcare systems [
1]. This phenomenon occurs when microorganisms, including bacteria, fungi, and viruses, develop the ability to survive exposure to drugs that were previously effective against them [
2]. In bacterial infections, resistance can lead to persistent infections, therapeutic failures, and increased mortality. Similarly, the rise of resistant fungal pathogens, particularly in hospital settings, has become an increasing concern for immunocompromised patients [
3].
Certain bacterial species are particularly problematic due to their high levels of resistance and association with severe infections. Methicillin-resistant
Staphylococcus aureus (MRSA) and vancomycin-resistant Enterococci (VRE) are notable examples. MRSA resists beta-lactam antibiotics, while VRE shows resistance to vancomycin, a last-resort treatment for severe infections [
2,
3]. These pathogens are commonly implicated in bloodstream infections, pneumonia, surgical site infections, and endocarditis, frequently necessitating the use of less effective or more toxic alternative therapies, which can prolong hospitalization and increase the risk of adverse effects [
2,
3].
Fungal pathogens, including
Candida albicans and
Candida glabrata, have also emerged as major contributors to healthcare-associated infections, especially among immunocompromised individuals such as transplant recipients, cancer patients undergoing chemotherapy, or patients with chronic illnesses [
4]. Resistance to commonly used antifungals, such as azoles and echinocandins, complicates treatment and often requires prolonged therapy or higher doses, increasing the risk of toxicity [
5]. The rising incidence of resistant fungi mirrors the challenges observed with bacterial pathogens, emphasizing the urgent need for novel therapeutic approaches.
The economic and social burden of antimicrobial resistance is substantial. Resistant infections frequently require costly treatment regimens and extended hospital stays, placing additional strain on healthcare systems [
5,
6]. Beyond financial implications, AMR is associated with prolonged illness, increased morbidity, and reduced quality of life for affected patients, underscoring the importance of developing new, effective, and safe antimicrobial agents.
Natural compounds with antimicrobial properties have attracted increasing interest as potential alternatives or adjuncts to conventional drugs. Among these, terpenoids—secondary metabolites widely found in plants—exhibit diverse biological activities, including antibacterial, antifungal, antiviral, and anti-inflammatory effects [
7,
8,
9,
10]. Historically used in traditional medicine, terpenoids are now being explored for modern therapeutic applications due to their multifaceted mechanisms of action, which can reduce the likelihood of resistance development [
11,
12]. They generally display low toxicity toward human cells, are biodegradable, and have minimal environmental impact, making them attractive candidates for sustainable antimicrobial strategies [
13,
14]. Recent research has also examined the potential of terpenoids to act synergistically with existing antimicrobial drugs, enhancing their efficacy and helping to curb resistance [
14,
15].
Among terpenoids GA, a monoterpenoid alcohol present in essential oils from plants such as lemongrass (
Cymbopogon citratus), rose (
Rosa spp.), lemon balm (
Melissa officinalis), and various citrus fruits, has demonstrated notable antimicrobial activity [
16,
17,
18]. Though primarily known for its fragrance and use in the food and cosmetic industries, GA exhibits inhibitory effects against Gram-positive bacteria, including
Streptococcus pyogenes and
Listeria monocytogenes, as well as fungal species such as
Candida albicans and
Candida glabrata (
Figure 1) [
19,
20,
21,
22].
GA exhibits a broad spectrum of biological activity, particularly against pathogenic microorganisms. Studies have shown that it is active against both Gram-positive bacteria and fungal pathogens, which are frequent causes of hospital-acquired and chronic infections. Notably, GA demonstrates strong activity against
Streptococcus species, including
Streptococcus pyogenes, responsible for infections such as sore throat, pneumonia, and skin diseases, as well as
Listeria monocytogenes, a pathogen causing listeriosis, which is especially dangerous for pregnant women, newborns, and immunocompromised individuals. Additionally, GA is effective against
Candida species, including
Candida albicans and
Candida glabrata, which are associated with vaginal, oral, and urinary tract infections [
21,
22]. These properties highlight GA’s potential as a therapeutic agent against infections caused by microorganisms resistant to conventional antibiotics and antifungal drugs [
23].
In vitro experiments demonstrate that GA inhibits the growth of various bacterial strains and reduces fungal colony formation, indicating its potential to combat infections. Its antimicrobial mechanism involves disruption of microbial cell membranes. In bacteria, GA destabilizes lipoprotein structures of the membrane, increasing permeability and causing the loss of essential cellular components. In
Candida fungi, GA disrupts membrane integrity and inhibits enzymes critical for growth and reproduction. These actions result in a marked reduction of microbial viability, making GA a promising agent for managing multidrug-resistant infections [
24,
25].
Importantly, GA exhibits low toxicity in humans at standard therapeutic doses, providing a safe alternative to conventional antimicrobial agents. Toxicological studies report no irritating or toxic effects at typical concentrations, further supporting its clinical applicability [
26]. Moreover, GA is a natural, biodegradable compound, minimizing environmental risks associated with its use [
27,
28]. Taken together, these characteristics reinforce the potential of GA as an effective and safe antimicrobial agent, particularly in the context of rising resistance to antibiotics and antifungal medications [
29,
30].
The antimicrobial activity of GA involves complex interactions with microbial cell membranes. In Gram-positive bacteria such as
Streptococcus spp. and
Listeria monocytogenes, GA destabilizes and damages the cell membrane by interacting with phospholipids and proteins, leading to increased permeability. This membrane disruption results in the loss of key cellular components, such as potassium ions (K+), which are critical for maintaining homeostasis, and impairs enzymatic activity and metabolic processes including protein transport and nucleic acid synthesis, ultimately causing bacterial cell death [
31,
32].
Gram-negative bacteria, including
Escherichia coli and
Pseudomonas aeruginosa, are less susceptible to GA due to their additional outer lipopolysaccharide layer, which provides a protective barrier. Nevertheless, GA can interfere with adhesion properties, reduce host-cell penetration, and potentially disrupt biofilm formation, limiting bacterial colonization and pathogenicity [
33,
34,
35].
In fungi, GA targets the cell membrane, which contains ergosterol, a lipid essential for membrane stability. By interacting with ergosterol, GA disrupts membrane integrity, disturbs ion transport, and compromises homeostatic processes. Furthermore, GA inhibits enzymes involved in lipid and fatty acid biosynthesis, impairing fungal growth, reproduction, and survival [
36,
37,
38]. In vitro studies confirm GA’s inhibitory effects on
Candida albicans and
Candida glabrata, supporting its potential as an antifungal agent [
36,
37,
38].
Overall, GA exerts its antimicrobial effects through multifaceted mechanisms, including membrane destabilization and metabolic interference, resulting in the elimination of pathogenic microorganisms. These mechanisms underscore GA’s potential to address infections caused by drug-resistant bacteria and fungi [
36,
37].
The present study aimed to evaluate the antimicrobial activity of GA against selected Gram-positive and Gram-negative bacteria and fungal pathogens, including strains resistant to conventional therapies. Given the global rise of drug-resistant infections, identifying novel therapeutic agents is critical. GA’s biochemical properties make it a promising alternative to antibiotics and antifungals, particularly for hospital-acquired infections caused by resistant strains. This study not only assessed GA’s antimicrobial efficacy but also investigated its mechanisms of action, focusing on effects on microbial membrane structure and metabolic processes, which are essential for optimizing its clinical application.
Additionally, this study explored GA’s potential in hospital infection control, particularly for multidrug-resistant strains, and its use in cosmetics, personal care products, and disinfectants. Its low toxicity and biodegradability make GA a suitable ingredient for formulations such as creams, deodorants, and cleaning agents, providing a safe antimicrobial alternative. This research also evaluated potential synergistic effects between GA and other antimicrobial compounds, which could enhance efficacy and reduce the risk of resistance development.
Finally, microbiological studies of creams containing varying GA concentrations assessed its effectiveness in limiting microbial growth, contributing to product safety. The anticancer potential of GA was also examined using human colon cancer (LoVo) and glioma-like (U-87MG) cell lines, yielding insights into its possible applications beyond antimicrobial therapy.
2. Materials and Methods
2.1. Raw Materials, Cream Base and Microbiological Media
For the experiments, geraniol (GA, purity ≥ 99%, Acros Organics, Poznań, Poland) was employed as the active compound. As a carrier for topical formulations, a commercial cosmetic base (CALAYA, Cosibella, Leeds, UK) designed for natural preparations was utilized. The composition of the base included aqua, Helianthus annuus (sunflower) seed oil, polysorbate 20, cetyl alcohol, glyceryl stearate, phenoxyethanol, carbomer, potassium sorbate, and sodium hydroxide.
Microbiological culture media were sourced from Graso Biotech (Jabłowo, Poland). The following substrates were applied depending on the experimental design: Mueller–Hinton II agar, Columbia agar with 5% defibrinated sheep blood, plate count agar (PCA), chocolate agar, mannitol salt agar, brain heart infusion (BHI) broth, and D/E neutralizing broth. For sample preparation and disinfection procedures, 0.9% sodium chloride (Polpharma, Starogard Gdański, Poland) and 70% ethanol (Chempur, Poznań, Poland) were also used [
38].
2.2. Microorganisms
To assess the antimicrobial properties of geraniol (GA), a broad panel of microorganisms was employed, including Gram-positive and Gram-negative bacteria as well as yeast-like fungi [
38].
- –
Gram-positive bacteria: This study covered both reference and clinical isolates. Among the reference strains were
Staphylococcus aureus ATCC 29213 and
Enterococcus faecalis ATCC 29212. The clinical collection included multidrug-resistant strains such as methicillin-resistant
Staphylococcus aureus (MRSA), methicillin-resistant
Staphylococcus epidermidis (MRSE), vancomycin-resistant
Enterococcus faecalis (VRE VanB), and
Enterococcus faecium carrying VanA and VanB resistance determinants. Additionally, pathogenic streptococci (
Streptococcus pyogenes,
S. pneumoniae,
S. agalactiae) and
Listeria monocytogenes were tested [
38].
- –
Gram-negative bacteria: The reference set comprised
Escherichia coli ATCC 25922,
Klebsiella pneumoniae ATCC 700603,
Pseudomonas aeruginosa ATCC 27853, and
Haemophilus influenzae ATCC 49766. Clinical isolates included extended-spectrum β-lactamase (ESBL) producing
K. pneumoniae and
E. coli,
E. coli with OXA-48 carbapenemase,
Enterobacter cloacae ESBL,
Neisseria gonorrhoeae, carbapenem-resistant
P. aeruginosa (VIM), multidrug-resistant
Acinetobacter baumannii, and
Salmonella spp [
38].
- –
Yeast-like fungi: The fungal panel involved both reference strains (
Candida albicans ATCC 10231 and ATCC 24433) and clinically relevant isolates, including
Candida parapsilosis,
C. glabrata, and
C. dubliniensis [
38].
All microbial strains were obtained from the strain collection maintained at the Regional Multi-Specialist Hospital in Gorzów Wielkopolski (Poland) [
38].
2.3. Assessment of Antibacterial Activity of GA
The disk diffusion method was used for the preliminary assessment of antimicrobial activity. Bacterial strains were cultured on Columbia media with 5% sheep blood or on chocolate agar at 37 °C. Suspensions of microorganisms were prepared in 0.9% NaCl solution, adjusting the density to the 0.5 McFarland standard using a densitometer (bioMérieux SA, Marcy-l’Étoile, France). After inoculation of Mueller–Hinton II Agar and Columbia Agar with 5% sheep blood, sterile disks (diameter 6 mm) soaked in 20 μL of GA solution at concentrations ranging from 10 to 70 µg/mL were placed on them. The selected concentration range was based on preliminary experiments, aiming to identify doses that produced measurable antimicrobial effects without causing excessive cytotoxicity [
38].
Control discs were soaked in 0.9% saline (negative control) and 70% ethanol (positive control). The use of 70% ethanol as a positive control was chosen because it is a standard solvent with known antimicrobial activity, allowing comparison of GA’s effects relative to a benchmark. The plates were incubated for 24 h at 37 °C, and then the diameters of the growth inhibition zones were measured, including the diameter of the disc [
38].
2.4. Preparation of Creams with GA
For the purpose of the study, a series of topical formulations containing geraniol (GA) at concentrations of 0.5%, 1.5%, 2.5%, 4%, 8%, and 12% (w/w) were prepared.
The preparation process was as follows:
- –
The commercial cream base (CALAYA) was first gently warmed in a water bath (approximately 40 °C) to achieve a smooth, semi-fluid texture.
- –
Precisely weighed quantities of GA were then incorporated into the base using an analytical balance, corresponding to 5, 15, 25, 40, 80, and 120 mg of GA per 1 g of base, respectively.
- –
Each formulation was homogenized with a laboratory mixer for about 5 min to ensure a uniform distribution of the active compound.
- –
The creams were subsequently allowed to cool to ambient temperature under slow mixing, which helped preserve their stability and consistency.
- –
Final products were transferred aseptically into sterile 10 mL containers, sealed, and stored under refrigerated conditions (4 °C) until experimental use.
This standardized method guaranteed reproducibility and accurate dosing of GA in all formulations intended for biological evaluation [
38].
2.5. Microbiological Stability of GA Creams
The microbiological stability of the prepared GA-containing creams was examined in a two-step procedure.
Step 1—Direct inoculation:
Aliquots of each formulation were streaked on selective and nonselective culture media suitable for the detection of aerobic bacteria and fungi. The media used included plate count agar (PCA), mannitol salt agar, MacConkey agar, brain heart infusion (BHI) broth, and D/E neutralizing broth. Inoculation was carried out with sterile 10 µL calibrated loops. The samples were incubated at 37 °C for 24 h. Following incubation, colonies that appeared on the solid substrates were counted, and the microbial load was expressed as colony-forming units per milliliter (CFU/mL) [
38].
Step 2—Subculturing from liquid media:
After incubation, liquid cultures were transferred onto solid agar plates using sterile calibrated loops in order to verify the presence of even minimal microbial contamination. These plates were again incubated at 37 °C for 24 h, and any emerging colonies were identified and analyzed [
38].
The cream base without GA served as the negative control and underwent the same testing conditions. Throughout the study, formulations were stored at 4 °C. To ensure reproducibility, all experiments were conducted in triplicate [
38].
2.6. GA Anticancer Studies
For cytotoxicity assays, two human cell lines were employed: LoVo colon adenocarcinoma cells (ATCC, Manassas, VA, USA) and U-87MG glioblastoma cells (Sigma-Aldrich, St. Louis, MO, USA).
Cell culture conditions:
- –
LoVo cells were maintained in F-12K medium (Genos).
- –
U-87MG cells were cultured in EMEM (Sigma-Aldrich).
Both culture media were enriched with 10% fetal bovine serum (FBS), 2 mM L-glutamine, 1% nonessential amino acids (NEAA), 1 mM sodium pyruvate, and an antibiotic mixture (penicillin 100 IU/mL, streptomycin 10 µg/mL; Sigma-Aldrich). All cultures were incubated at 37 °C in a humidified atmosphere (95%) containing 5% CO2.
Because geraniol is poorly soluble in water, dimethyl sulfoxide (DMSO, Sigma-Aldrich) was used to prepare stock solutions [
38].
Assessment of cytotoxic/cytostatic activity:
Cell viability and proliferation were evaluated using the MTT assay, according to the following procedure:
Cells were exposed to varying concentrations of GA for 72 h.
Subsequently, 20 µL of MTT solution (2.5 mg/mL) was added to each well, followed by 3 h incubation.
After removal of the medium, formazan crystals were dissolved in 200 µL of DMSO.
Absorbance was recorded with a UV-M340 microplate reader (Asys Hitech GmbH, Eugendorf, Austria), and raw data were processed with MicroWin 2000 software. Results were further analyzed in MS Excel [
38].
Statistical analysis:
Data were processed using Statistica 13.3 (TIBCO). As the datasets deviated from a normal distribution, nonparametric methods were applied. Intragroup differences and comparisons between GA concentrations were evaluated using the Wilcoxon test, with statistical significance defined as follows:
- –
p ≤ 0.05 (*);
- –
p ≤ 0.01 (**);
- –
3. Results
3.1. Antimicrobial Activity of GA Against Gram-Positive Bacteria
Table 1 and
Figure 2 and
Figure 3 present the results of the analysis of the antimicrobial activity of GA against selected strains of Gram-positive bacteria, including species of the genera
Staphylococcus,
Enterococcus,
Streptococcus, and
Listeria monocytogenes. The obtained results indicate a diverse response of the tested microorganisms to the action of GA, which is important from the perspective of understanding its potential applications as an antibacterial agent.
Studies have shown that GA, as a monoterpene, exhibits antimicrobial activity against Gram-positive bacteria. Its action is associated with destabilization of bacterial cell membranes, increased permeability of lipid membranes, and disruption of membrane-bound enzyme functions. As a result, the integrity of the cytoplasmic membrane is lost, ions and metabolites leak out, and bacterial cell death occurs. At the same time, it was observed that the effectiveness of GA can vary depending on the structural and biochemical characteristics of the cell wall of individual strains [
39,
40,
41,
42,
43].
For S. aureus ATCC 29213, S. aureus MRSA, and S. epidermidis MRSE strains, the inhibition zones showed significant differences compared to the negative control. S. aureus ATCC 29213 strain showed an inhibition zone of 11.0 ± 0.0 mm in diameter, which was significantly larger than the negative control (6.0 ± 0.0 mm) and similar to the positive control (15.0 ± 0.0 mm), with the difference considered statistically significant (p ≤ 0.001). For S. aureus MRSA and S. epidermidis MRSE strains, a mean inhibition zone of 17.4 ± 0.5 mm was observed, which was statistically significantly higher than the positive control (14.0 ± 0.0 mm) and the negative control (6.0 ± 0.0 mm), with the difference assessed as significant (p ≤ 0.05). In conclusion, GA is effective in destabilizing cytoplasmic membranes of staphylococci, including those resistant to methicillin (MRSA).
In the case of E. faecalis ATCC 29212 (6.0 ± 0.0 mm) and E. faecium VRE VanB (12.0 ± 0.0 mm), GA showed low efficacy, which may suggest the presence of a thick peptidoglycan layer in the cell wall of these bacteria and the effective action of ABC-type membrane pumps, which actively remove lipophilic compounds from the cell interior. The difference in the inhibition zone between E. faecalis ATCC 29212 and E. faecium VRE VanB was statistically significant (p ≤ 0.001), indicating that structural differences in the cell wall may affect the antimicrobial activity of GA.
In contrast, E. faecium VRE VanA demonstrated a very high sensitivity to GA (GA), with a mean zone of inhibition of 20.2 ± 0.4 mm. According to the predefined criteria for interpreting antimicrobial activity, this places the strain in the “very sensitive” category, indicating a strong inhibitory effect. The observed inhibition was statistically significant (p ≤ 0.05), confirming that the effect is unlikely to be due to random variation. These results suggest that GA exhibits potent antimicrobial activity even against highly resistant strains such as VRE VanA, highlighting its potential as an effective agent for targeting multidrug-resistant Enterococcus faecium in topical or clinical applications. The pronounced inhibitory effect may be related to GA’s known mechanisms of disrupting bacterial cell membranes and interfering with cellular metabolism, which warrants further investigation.
In the case of S. pyogenes and S. pneumoniae, the largest inhibition zones were noted, amounting to 13.6 ± 0.5 mm and 25.2 ± 0.7 mm, respectively. The value for S. pneumoniae was statistically higher than the negative control (6.0 ± 0.0 mm) and similar to the positive control (15.0 ± 0.0 mm), which was assessed as significant (p ≤ 0.001). Similarly, for S. agalactiae (18.8 ± 1.0 mm), the inhibition zone was significantly larger than the negative control (6.0 ± 0.0 mm) and the positive control (12.0 ± 0.0 mm), which was demonstrated with statistical significance (p ≤ 0.05). Streptococci are characterized by a thinner cell wall and a lack of advanced membrane pump mechanisms, which may explain their higher sensitivity to GA.
In general, the greatest antimicrobial activity of GA was observed against strains with thinner cell walls, such as S. pneumoniae, S. agalactiae, and S. pyogenes, which may be due to greater membrane permeability to monoterpenes.
In the case of L. monocytogenes, a growth inhibition zone of 16.4 ± 0.8 mm in diameter was obtained. This bacterium is known for the elasticity of the cytoplasmic membrane, which allows it to partially adapt to the presence of lipophilic compounds. However, GA probably interferes with the functioning of membranes by destabilizing phospholipid structures, which explains the moderate sensitivity of this pathogen.
The differences in the response of Gram-positive bacterial strains to GA are due to their different structural and biochemical properties. Strains with thick cell walls equipped with membrane pump mechanisms (e.g., Enterococcus faecalis) show lower sensitivity, whereas streptococci with thinner cell walls are more susceptible to GA. These results suggest that GA may be an effective antimicrobial agent against selected Gram-positive pathogens, but its efficacy may be limited by the adaptive mechanisms of some strains.
3.2. Antibacterial Activity of GA Against Gram-Negative Bacteria
Table 2 and
Figure 4 and
Figure 5 show the results of the analysis of the antimicrobial activity of GA against selected strains of Gram-negative bacteria. The studies showed a varied sensitivity of individual strains to GA, which indicates its selective effectiveness as an antibacterial agent. The results were compared with the negative control (0.9% NaCl) and the positive control (70% ethanol). The zones of growth inhibition (means ± standard deviation) for each of the tested bacteria illustrate the varied response to the presence of GA.
GA, as a hydrophobic monoterpene, acts by interacting with bacterial cytoplasmic membranes, leading to increased membrane permeability, destabilization of lipid structures, and disruption of membrane protein function. However, the structure of Gram-negative bacterial cell walls, which contain an additional outer membrane composed of lipopolysaccharides (LPSs), may hinder GA’s access to the inner membrane, which results in its variable efficacy [
44,
45,
46,
47,
48,
49].
The results presented in
Table 2 show the antimicrobial effect of GA against different bacterial strains. GA shows variable efficacy depending on the microorganisms tested, suggesting that its effect is dependent on the type of bacteria. In the case of
Klebsiella pneumoniae ATCC 700603, no significant antimicrobial activity of GA was observed, as the inhibition zone was 6 mm, which is comparable to the negative control (0.9% NaCl), and the difference was statistically significant (
p ≤ 0.001). In the case of the
Klebsiella pneumoniae NDM (multidrug-resistant) strain, GA showed a clear antimicrobial effect, with a larger inhibition zone (17.8 mm) than the positive control (12 mm), which was assessed as statistically significant (
p ≤ 0.05). In the case of
Klebsiella pneumoniae ESBL, GA showed moderate efficacy, with a smaller inhibition zone (11.6 mm) compared to the positive control (15 mm), which was also statistically significant (
p ≤ 0.05).
In the case of Escherichia coli ATCC 25922 strains, GA showed a fairly strong antimicrobial effect, with a zone of inhibition of 15.8 mm, which is comparable to the positive control (14 mm), and the difference with the negative control (6 mm) was statistically significant (p ≤ 0.05). Similar results were obtained for the Escherichia coli OXA-48 strain, where GA also induced a significant zone of inhibition (15.4 mm), slightly higher than the positive control (13 mm), with the difference assessed as statistically significant (p ≤ 0.05). In the case of Escherichia coli ESBL, the zone of inhibition was 13.6 mm, which was smaller than that of the positive control (15 mm), but also showed statistical significance (p ≤ 0.05).
With respect to Pseudomonas aeruginosa ATCC 27853, GA did not induce an antimicrobial effect, with an inhibition zone of 6 mm, which was comparable to the negative control, and the difference was statistically significant (p ≤ 0.001). With respect to the Pseudomonas aeruginosa VIM strain, GA showed a weaker antimicrobial effect, with an inhibition zone of 10.8 mm, which was significantly larger than the negative control (6 mm) but smaller than the positive control (10 mm) (p ≤ 0.05).
The Haemophilus influenzae ATCC 49766 strain was sensitive to GA, showing a large inhibition zone (39 mm), which was statistically significant compared to the positive control (15 mm) and the negative control (6 mm) (p ≤ 0.05). In contrast, in the case of the MDR Acinetobacter baumannii strain, GA showed low efficacy, with an inhibition zone of only 10 mm, which was statistically significant compared to the positive control (15 mm) (p ≤ 0.001).
In the case of Enterobacter cloacae ESBL, the inhibition zone was 12 mm, which was also statistically significant compared to the positive control (13 mm) (p ≤ 0.001). Salmonella sp. showed a low sensitivity to GA (13 mm), which was also statistically significant compared to the positive control (14 mm) (p ≤ 0.001). Finally, Neisseria gonorrhoeae was very sensitive to GA, with a zone of inhibition of 40 mm, which was significantly different compared to both controls (p ≤ 0.001).
All the above results suggest that GA exhibits varying antimicrobial efficacy depending on the bacterial strain, with more pronounced effects against some multidrug-resistant strains and microorganisms, such as Haemophilus influenzae and Neisseria gonorrhoeae, and less activity against other strains, such as Klebsiella pneumoniae ATCC 700603 or Pseudomonas aeruginosa ATCC 27853.
The diverse response of Gram-negative bacteria to GA is due to different structural properties of membranes and cell walls, the presence of membrane pump mechanisms, and differences in membrane lipid composition. Bacteria with more permeable cytoplasmic membranes, such as H. influenzae and N. gonorrhoeae, showed high sensitivity to GA, whereas bacteria with advanced defense mechanisms, such as K. pneumoniae ATCC 700603 or P. aeruginosa ATCC 27853, were practically insensitive. The conclusions from these studies may be important for the further development of GA as an antibacterial agent, especially in the context of combating pathogens causing respiratory and urogenital infections.
3.3. GA Activity Against Yeast-like Fungi
Table 3 and
Figure 6 and
Figure 7 present the results of the analysis of the antimicrobial activity of GA (GA) against selected strains of yeast-like fungi of the
Candida genus. The results clearly indicate the significant effectiveness of GA in inhibiting the growth of these microorganisms. The obtained results were compared with the negative control (0.9% NaCl) and positive control (70% ethanol).
GA, as a lipophilic monoterpene, exerts antifungal activity through direct interaction with fungal cell membranes. This mechanism involves disruption of the lipid bilayer organization of the membrane, increasing its permeability, and inhibition of key membrane enzymes such as ATPases. As a result of these processes, the membrane integrity is lost, which leads to fungal cell death [
50,
51].
In the analyzed studies on the activity of GA against Candida fungi, the results show varying activity depending on the species, with GA showing strong antifungal activity against most of the tested strains.
Both Candida albicans strains were characterized by a clear sensitivity to GA, as confirmed by inhibition zones of 34.0 ± 0.8 mm and 36.3 ± 1.0 mm, respectively. The differences from the negative control (0.9% NaCl) were statistically significant (p ≤ 0.05), suggesting that GA effectively inhibits the growth of these strains. These results indicate the high potential of GA as an antifungal agent in the treatment of infections caused by C. albicans, which is one of the most common fungal pathogens.
Candida glabrata, which tends to be more resistant to traditional antifungal agents than other Candida species, showed a very high sensitivity to GA, with a clear inhibition zone of 40.0 ± 0.0 mm. The difference from the positive control (ethanol 70%) was highly statistically significant (p ≤ 0.001). This is an interesting result, as it suggests that GA may be a promising agent in the treatment of infections caused by C. glabrata strains, which are often resistant to traditional therapies.
For Candida parapsilosis, a zone of inhibition of 31.0 ± 1.2 mm was obtained, which also demonstrates the significant efficacy of GA in inhibiting the growth of this strain. The difference was statistically significant (p ≤ 0.05), suggesting that GA may be an effective agent in the fight against this pathogen, which can be particularly problematic in the hospital environment, especially in patients with weakened immune systems.
Candida dubliniensis, which is closely related to C. albicans, also showed high sensitivity to GA, reaching a zone of inhibition of 32.8 ± 0.5 mm. This value was statistically significant (p ≤ 0.05), which highlights the efficacy of GA in combating various Candida strains, including being less common but equally problematic for human health.
GA demonstrated notable antifungal activity against various Candida species, with the strongest effect observed for C. glabrata. Variability in susceptibility among strains is likely linked to differences in cell membrane properties. These results highlight the potential of GA as a natural antifungal agent for use in cosmetic, pharmaceutical, and healthcare product formulations.
3.4. Microbiological Stability of GA in Creams
The results of the experiment on the microbiological stability of GA in creams indicate its strong antimicrobial properties. It turned out that GA, regardless of the concentration, effectively inhibits the growth of bacteria in the tested cream samples. This analysis includes different culture media and GA concentrations and also indicates the potential applications of GA in the cosmetic and pharmaceutical industries.
Two standard growth media were employed in this study: Brain Heart Infusion (BHI) Broth and D/E Neutralizing Broth. BHI is a nutrient-rich medium widely used in microbiological research due to its ability to support the growth of a broad spectrum of microorganisms, including both Gram-positive and Gram-negative bacteria as well as fungi. In contrast, D/E Neutralizing Broth has been specifically designed to inactivate antimicrobial chemicals such as preservatives, disinfectants, and antibiotics, thereby enabling accurate recovery and growth of microorganisms exposed to such agents. The use of these two complementary media allowed for a comprehensive evaluation of the antimicrobial properties of geraniol (GA) under different experimental conditions.
Across the entire concentration range tested (0.5–12%), no bacterial growth was observed in either medium, as evidenced by a complete absence of colony-forming units (0 CFU/mL). This consistent outcome strongly suggests that GA exerts pronounced bactericidal and/or bacteriostatic effects, effectively suppressing microbial proliferation irrespective of the growth conditions.
A particularly noteworthy observation is the lack of variability in GA’s antimicrobial efficacy across different concentrations. Even at the lowest tested concentration (0.5%), GA completely inhibited microbial growth to the same extent as at the highest concentration (12%). This finding indicates that the minimum inhibitory concentration (MIC) of GA is relatively low, which is advantageous for potential applications in cosmetic, pharmaceutical, and food products. The ability to achieve strong antimicrobial effects at low concentrations reduces the likelihood of adverse effects, minimizes production costs, and facilitates regulatory compliance in consumer formulations.
Equally significant is the outcome observed with D/E Neutralizing Broth. Despite its capacity to neutralize residual antimicrobial compounds, no bacterial recovery occurred in this medium following GA exposure. This result demonstrates that GA maintains its antimicrobial activity even in the presence of neutralizing agents, which is of particular relevance in complex formulations that contain additional chemicals such as preservatives, emulsifiers, or stabilizers. Consequently, GA may retain efficacy in real-world product matrices, where interaction with multiple excipients could otherwise diminish antimicrobial potency.
Taken together, these results strongly support the potential of GA as a natural antimicrobial agent with robust stability and wide applicability. Its dual bacteriostatic and bactericidal activity, maintained across various media and concentrations, underscores its versatility. Moreover, the demonstrated effectiveness of GA in neutralizing environments suggests that it could be incorporated into formulations intended for long-term storage or challenging application settings.
From a translational perspective, GA emerges as a promising candidate for use in cosmetics (e.g., creams, lotions, and deodorants with antimicrobial functions), pharmaceutical preparations (e.g., antibacterial ointments, wound healing formulations, and topical antifungals), and food technology (as a natural preservative to inhibit microbial spoilage). The combination of broad-spectrum antimicrobial activity, low effective concentration, and stability in neutralizing conditions highlights GA’s relevance for further development as a safe, natural bioactive compound in diverse industrial sectors.
3.5. Anticancer Activity of GA
The obtained results show the cytotoxicity of GA on human colon cancer cells LoVo and human glioma cell line U87, measured as the percentage of cell survival at concentrations in the range of 10 to 70 μ/mL with respect to the control system, where the value of 100% viable cells was assumed.
For the LoVo line, at low concentrations (10–15 μg/mL), GA showed a slight cytotoxic effect (about 5–15%). However, at higher concentrations above 25 μg/mL, a clear cytostatic/cytotoxic effect was observed. In the case of the U87 line, a slight stimulating effect on the proliferation process and/or activity of mitochondrial enzymes was observed at low concentrations of GA (for concentrations of 10 and 15 μg/mL of about 8 and 9%, respectively), but such an effect was not observed in the LoVo line. Higher concentrations of GA (above 35 μg/mL) showed a clear cytostatic/cytotoxic effect for the U87 line cells (
Figure 8,
Figure 9,
Figure 10 and
Figure 11).
The patterns of the determined regression curves allowed us to calculate the IC50 values of GA (the concentration at which cell growth and proliferation are inhibited by 50% compared to control cells) for both cell lines. For the LoVo line, the IC50 was 32.1 μg/mL (95% confidence interval: 30.5–33.7 μg/mL), and for the U87 line, it was 41.3 μg/mL (95% CI: 39.0–43.6 μg/mL). IC50 values were determined using nonlinear regression analysis of dose–response curves obtained from three independent experiments, each performed in triplicate.
In recent years, there has been an increased interest in monoterpenes such as GA, among others, due to their chemopreventive and chemotherapeutic properties [
44]. Although there are more and more reports on the anticancer properties of GA, there are still many question marks, mainly related to its efficacy in various types of cancers and its diverse mechanism of action [
45]. The efficacy of GA has been demonstrated, among others, in prostate cancer cells PC-3 [
46], pancreatic cancer MIA PaCa-2 and pancreatic adenocarcinoma BxPC-3 [
47,
48], hepatocellular carcinoma HepG2 [
49], leukemia cells P388 [
50], melanoma B16 [
51], and human breast cancer MCF-7 [
52]. GA also inhibited the development of skin tumors in mice [
53] and reduced the mass and volume of tumors in mice with tumors derived from the A549 lung adenocarcinoma cell line [
54].
The presented results indicate a promising antitumor effect of GA on human colon cancer cells of the LoVo line (IC
50 = 32.1 μg/mL). We did not find any studies using a similar research system, but there are reports that tested the potential of GA in the treatment of similar types of cancers. In a study on human colon cancer cells of the Caco-2 line, GA (400 μM) prevented the formation of brush membranes and inhibited the expression of intestinal hydrolases. The antiproliferative effect of GA (400 μM) in combination with 5-fluorouracil (5-FU) (5 μM) was twice as strong as 5-FU in monotherapy [
55]. GA also exerted an antiproliferative effect on colon adenocarcinoma cells of the CT26 line [
56]. Moreover, it sensitized colon adenocarcinoma cells of the SW620 line to 5-FU [
57] and also increased the efficacy of 5-FU therapy in mice with colon cancer cell xenografts of the TC11 line. Additionally, GA and geranyl acetate were also analyzed by Qi et al. as compounds showing significant antitumor activity against the Colo-205 cancer cell line, with IC
50 values of 20 and 30 µM, respectively [
58].
In the case of the human glioma U87 line, our analyses showed that GA at lower concentrations (10–15 μg/mL) may have a weak promoting effect on the development of cancer cells, while at higher concentrations (>30 μg/mL) its anticancer potential is revealed (IC
50 = 41.3 μg/mL). GA is known to affect many signaling pathways associated with cancer, e.g., pathways involved in various biological processes, such as the cell cycle, cell survival and proliferation, apoptosis, autophagy, and metabolism [
59]. It is suggested that the observed pleiotropic effect of GA may eliminate some unfavorable features of cancer cells, thanks to which they can survive unfavorable conditions, related to inflammation or oxidative stress [
60]. It has also been shown that GA can penetrate the central nervous system from the bloodstream and supports the survival of dopaminergic neurons by increasing neurotrophic factors, reducing the expression of apoptosis markers and leading to the production of antioxidant enzymes [
61]. There are currently not many similar analyses of GA cytotoxicity on the U87 cell line; the only experiment we were able to find indicates that at a concentration of 1500 µM GA inhibited cell growth by 23% [
62]. The current state of knowledge of the role of GA in the treatment of brain tumors is little explored and requires further analyses in the future.
4. Discussion
Our study confirms the broad-spectrum antibacterial activity of GA, although its effectiveness depends on the type of microorganism. Among Gram-negative bacteria, Haemophilus influenzae and Neisseria gonorrhoeae were the most susceptible, likely due to their relatively permeable outer membrane, which facilitates the penetration of lipophilic compounds such as GA [
30,
63,
64,
65]. Similarly high susceptibility was observed in Gram-positive cocci, including Streptococcus pneumoniae and Streptococcus agalactiae, consistent with the absence of an outer lipid membrane and the predominance of peptidoglycan in the cell wall, allowing GA to destabilize membranes [
30,
31,
41].
However, limited susceptibility was noted in Enterococcus faecalis and vancomycin-resistant Enterococcus faecium (VRE), likely due to more developed defense mechanisms, including efflux pumps and thickened cell walls [
20,
25,
66,
67,
68]. Methicillin-resistant bacteria, such as Staphylococcus aureus MRSA and Staphylococcus epidermidis MRSE, showed moderate sensitivity, suggesting that GA could serve as an adjunctive agent in infections caused by beta-lactam-resistant strains, which is significant given the growing problem of antibiotic resistance [
28,
29].
GA also demonstrated notable antifungal activity, particularly against Candida albicans and Candida glabrata, including strains resistant to conventional antifungals [
21,
23,
36,
37,
38]. Variability in susceptibility among Candida species may be related to differences in membrane lipid composition and adaptive capacity, which aligns with previous observations for other monoterpenes such as limonene and linalool [
30,
63]. The efficacy of GA appears largely linked to its ability to destabilize cell membranes, while organisms with more complex protective barriers, such as Pseudomonas aeruginosa or Klebsiella pneumoniae, exhibited limited susceptibility [
63,
65,
66]. These findings suggest potential clinical and cosmetic applications for GA, especially in combination with compounds that enhance membrane permeability or inhibit efflux pumps, warranting further investigation.
Microbiological stability testing of creams showed that GA retains antibacterial activity across a wide concentration range (0.5–12%), fully inhibiting bacterial growth in various media (BHI, D/E Neutralizing Broth, PCA, MC, MSA). Re-analysis of the data revealed that the cream base (BZ) itself exhibits some inhibitory effect, comparable to GA formulations. This indicates that part of the observed activity in creams may be attributed to base components, highlighting the necessity of proper controls and quantitative studies to precisely assign the effect to active substances [
69,
70].
Figure 12 illustrates the differential efficacy of GA against Gram-positive and Gram-negative bacteria, fungi, and yeasts. Gram-negative bacteria contribute most to growth inhibition, reflecting the high susceptibility of H. influenzae and N. gonorrhoeae strains. Gram-positive bacteria show moderate susceptibility, influenced by both simpler cell wall structure and defense mechanisms such as efflux pumps. Fungi, particularly Candida species, show noticeable, though slightly lower, sensitivity, confirming GA’s broad-spectrum activity and suggesting directions for further research, e.g., combining GA with membrane-penetrating agents.
GA also exhibited dose-dependent cytotoxic effects against human colorectal cancer (LoVo) and glioblastoma (U87) cell lines. LoVo cells were moderately sensitive at 10–15 μg/mL, with an IC
50 of 32.1 μg/mL, consistent with previous studies on colorectal cancer models [
46,
47,
48,
49,
55,
58]. In U87 cells, a biphasic effect was observed: slight stimulation at low concentrations and cytotoxicity above 30 μg/mL (IC
50 41.3 μg/mL), likely due to specific metabolic and signaling characteristics of these cells [
51,
52,
53,
59,
60,
61,
62]. These results indicate GA’s potential as an anticancer agent, particularly for colorectal cancer, while highlighting the need for further mechanistic studies in glioblastoma and other brain tumor models.
In summary, our results confirm the broad antibacterial, antifungal, and anticancer potential of GA, while emphasizing the influence of microorganism specificity and formulation components. Study limitations include the contribution of the cream base to observed antibacterial activity and the need for further mechanistic investigations in cancer models. Future work should focus on optimizing formulations, examining synergistic effects, and elucidating the molecular mechanisms of GA action against both microorganisms and cancer cells, with comparative analysis to other terpenes with similar pharmacological properties.
5. Conclusions
GA demonstrates a broad spectrum of antibacterial and antifungal activity, with the highest susceptibility observed for Haemophilus influenzae, Neisseria gonorrhoeae, Streptococcus pneumoniae, and Streptococcus agalactiae. In contrast, Enterococcus spp., MRSA, and MRSE exhibited moderate or limited sensitivity, which may reflect the contribution of defense mechanisms such as efflux pumps and thicker cell walls. GA also showed significant antifungal activity against Candida albicans and C. glabrata, including strains resistant to conventional antifungal agents. Importantly, GA maintained antimicrobial efficacy across a wide concentration range (0.5–12%) and in different culture media. However, the activity observed in cream formulations may be partially attributable to the base itself, underscoring the need for rigorous controls in future experiments.
Beyond its antimicrobial properties, GA displayed anticancer potential with dose-dependent cytotoxic effects against LoVo (colon cancer) and U87 (glioma) cell lines. LoVo cells were moderately sensitive (IC50 = 32.1 µg/mL), whereas U87 cells demonstrated a biphasic response—slight stimulation at low concentrations and cytotoxicity above 30 µg/mL (IC50 = 41.3 µg/mL)—indicating cell type-specific differences in metabolism and signaling pathways.
Despite these promising results, several limitations must be acknowledged, including the possible contribution of formulation components to antimicrobial effects, the lack of in vivo data on cytotoxicity and anticancer efficacy, and the still limited understanding of GA’s molecular mechanisms in cancer cells.
Future research should focus on elucidating the molecular basis of GA activity, including its impact on cell membranes, efflux systems, signaling pathways, apoptosis, and oxidative stress. Studies should also be expanded to additional cancer cell lines and in vivo models to evaluate efficacy, selectivity, and potential synergistic interactions with established therapies. Furthermore, investigations into pharmacokinetics, long-term safety, and toxicity profiles are necessary, along with the development of optimized formulations—such as nanoparticles or carrier systems—to enhance therapeutic effectiveness while minimizing adverse effects.
In conclusion, GA combines broad-spectrum antimicrobial and antifungal activity, including efficacy against drug-resistant strains, with promising anticancer potential. Its stability across different formulations further supports its prospective applications in pharmaceutical, cosmetic, and food industries. These findings provide a strong rationale for continued investigation of GA as a natural therapeutic candidate.